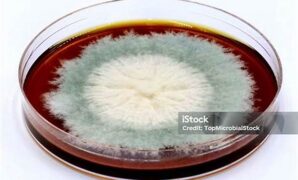
peran-kultur-jamur-pada-keju_0d1dcc15f.jpg

Pemanfaatan teknologi terus berkembang di berbagai bidang, tidak terkecuali bidang irigasi. Salah satu inovasi yang kini kian diminati adalah teknologi […]
BIOTECH VISTA
**streptococcus Thermophilus Meningkatkan Pencernaan**
Di dunia kesehatan, bakteri sering kali mendapatkan reputasi yang kurang baik. Namun, tidak semua bakteri bersifat merugikan. Satu jenis bakteri […]
Peran Kultur Jamur Pada Keju
Ketika membicarakan keju, banyak yang terlintas dalam pikiran hanyalah rasa dan tekstur lembutnya. Padahal, di balik keindahan keju, ada proses […]
Keunggulan Bioreaktor Generasi Terbaru
Di era modern ini, inovasi di bidang bioteknologi terus berkembang dengan pesat, dan bioreaktor menjadi salah satu komponen yang mengalami […]
Pertukaran Pengetahuan Tradisional Dan Ilmiah
Hidup di era globalisasi yang serba cepat ini membuat banyak dari kita berpikir dua kali tentang makna pengetahuan dan bagaimana […]
Penelitian Keamanan Vaksin Nano
Selama beberapa tahun terakhir, teknologi nano telah memberikan dampak besar dalam berbagai bidang, termasuk kedokteran. Salah satu inovasi yang menarik […]
Kerjasama Akademisi Dan Industri Pertanian
Dalam era modern ini, hubungan antara akademisi dan industri pertanian semakin vital. Keduanya tidak hanya berperan penting dalam pengembangan ilmu […]
Etika Genetika Dalam Perspektif Budaya
Di tengah kemajuan teknologi genetik yang pesat, muncul sebuah pertanyaan: Bagaimana kita, sebagai masyarakat, memahami dan menerapkan etika genetika dalam […]
Fermentasi Alami Mikroflora Keju
Keju merupakan salah satu kudapan lezat yang tak lekang oleh waktu. Memiliki berbagai jenis dan rasa, keju telah menjadi bagian […]
Karier Bioteknologi Di Industri Farmasi.
Bioteknologi telah menjadi salah satu bidang yang paling inovatif dan berkembang cepat dalam beberapa dekade terakhir. Dalam industri farmasi, bioteknologi […]